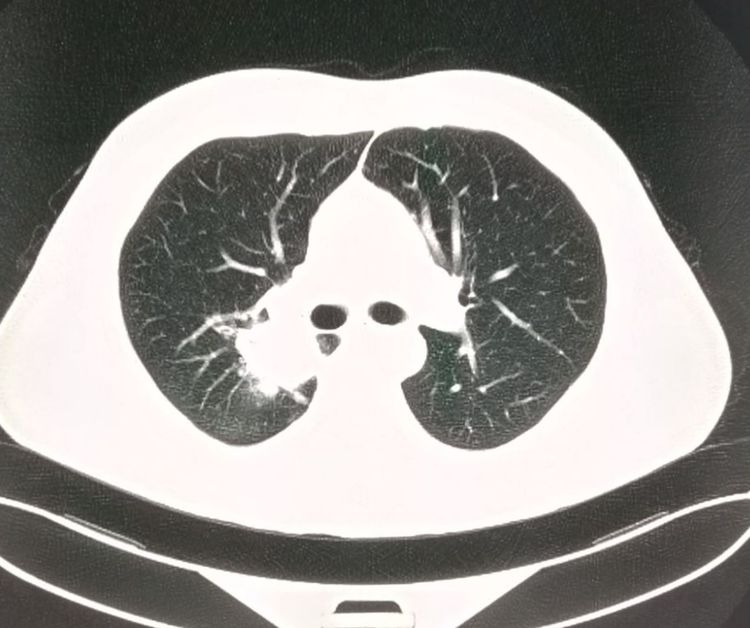
肺癌手术后胸腔内有碎肉怎么办,肺癌切除手术后有个空腔

加入头条半年以来,认识了很多读者朋友以及肿瘤病人家属,有一个很令人感动的地方:这些非医学专业群体的人们,对于肿瘤的诊治知识了解得很深!很前沿!在某些领域的知识深度甚至超越了很多医生!
为了攻克癌症,或者说为了从死神手中抢出生命,他们在用自己的方式努力!
这是对医生们的激励,也是鞭策!
豪大夫也希望通过自己的努力,尽量从接地气的角度,讲述一些肿瘤诊治方面的知识点,希望对某些朋友有用。
今天我们一起来认识一个肺癌手术后残腔的现象:
我们先看一个浸润性肺腺癌的病人,老年男性,咳嗽、胸背疼来医院就诊。
胸部CT发现右肺门旁的肿块,有分叶,有胸膜牵拉:

看过豪大夫肺结节系列文章的读者朋友可能就会判断出,这个肿瘤不是早期了!手术切除有复发风险,还需要配合后续治疗。
老人的家属最后选择赌一把,切掉了整个右肺(三个肺叶),配合术后化疗,之后定期复查。
今年已经是两整年了,最近的复查恢复很好,没有复发和转移:


后来老人的亲属拿着片子过来咨询,问右侧胸腔大量可见包裹性积液,是什么意思?
这其实是一个术后残腔,不是复发或转移,不必紧张。
什么叫术后残腔呢?
一侧全肺切除或某个肺叶切除后,由胸腔表面的胸膜包裹而成的腔隙就是术后残腔,里面包含一些半透明的浆液性液体,在胸部CT图片上,显示为低于胸壁软组织的密度(略高于水的密度)。
随着时间的推移,某些残腔可以逐渐变小,但仅有大约20%的人会完全吸收闭塞,其余80%的人会长期存在。
边缘的胸膜可以逐渐发生钙化。
我们再看一例全肺切除术后7年的术后残腔来加深理解:
下图是一位有点消瘦的老爷子,吸烟接近50年,咳嗽、痰中带血,胸部CT加支气管镜发现左侧肺鳞癌,肿瘤内部已经形成了空洞:

在前面的“豪大夫讲肺结节”系列中,我们提到过伴有空洞形成的肺鳞癌预后差,中位生存期平均只有17个月,而没有空洞者,可以达到92个月,差异巨大。
这是因为空洞型肺癌生长更迅速,病理上更容易发生坏死;更容易侵犯血管、淋巴管和胸膜。
在周围型肺癌中,肺鳞癌的空洞发生率大约是17%,腺癌是7%。
这位老爷子的家属全面考虑后选择冒险赌一把,做了左侧全肺切除。
手术很成功!
术后第3年复查的时候:

我们可以看到左侧胸腔形成了术后残腔。
而到今年已经是第7个年头了,最近一次的复查依然良好:

并且我们可以看到,在残腔的周围,已经发生了斑点状的胸膜钙化(白色斑点状影)。
我们上面提到过,随着时间的推移,边缘胸膜可以发生钙化,这一点是吻合的。
这也是一位幸运的老人。
好,关于肺癌术后残腔的问题就解释到这里,希望对某些读者朋友有用。
如果还有其他疑问,欢迎大家在留言区提问,我会尽量回答。
另外要申明一下,最近很多朋友咨询肿瘤治疗方面的知识,豪大夫是影像科医生,专业是影像诊断,对治疗方面的知识底蕴不够,不敢多言,希望朋友们谅解。
感谢大家的阅读和关注!